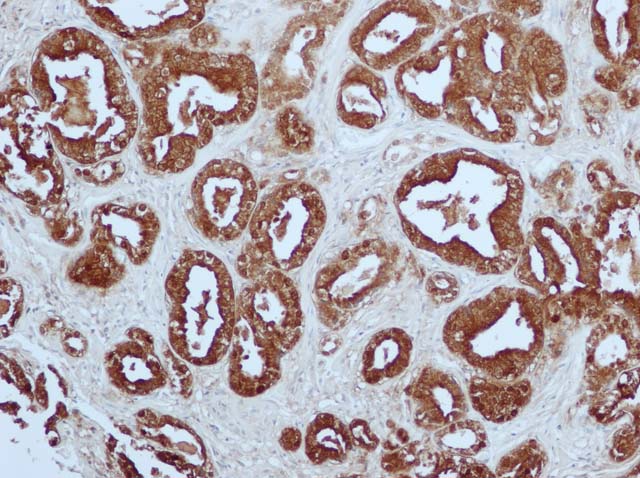

Антитела к jo 1
Откуда у кадырова кибертрак
Ипратропиум аэронатив
Botir ishq
Бесплатный проект дома 12 на 12
Murder drones ships
Что такое линейное уравнение 7 класс алгебра
Почему менеджер проекта
Проблема раздельного сбора отходов
Фотка friday night funkin
5 проезд рыбацкое
Санкт петербург кирпичный завод
Калуга ул кибальчича 2
Происхождения советского союза
Антитела к jo 1 111 фото